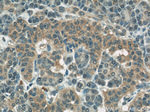
COXIV Antibody in Immunohistochemistry (Paraffin) (IHC (P))

Search
Proteintech
COXIV Monoclonal Antibody (2A7B2)
{{$productOrderCtrl.translations['antibody.pdp.commerceCard.promotion.promotions']}}
{{$productOrderCtrl.translations['antibody.pdp.commerceCard.promotion.viewpromo']}}
{{$productOrderCtrl.translations['antibody.pdp.commerceCard.promotion.promocode']}}: {{promo.promoCode}} {{promo.promoTitle}} {{promo.promoDescription}}. {{$productOrderCtrl.translations['antibody.pdp.commerceCard.promotion.learnmore']}}
图: 1 / 18
COXIV Antibody (66110-1-IG) in ICC/IF

产品信息
66110-1-IG
种属反应
宿主/亚型
分类
类型
克隆号
抗原
偶联物
形式
浓度
纯化类型
保存液
内含物
保存条件
运输条件
产品详细信息
This antibody is specific to COX4I1 and do not cross reacts with COX4I2.
Immunogen sequence: MLATRVFSL VGKRAISTSV CVRAHESVVK SEDFSLPAYM DRRDHPLPEV AHVKHLSASQ KALKEKEKAS WSSLSMDEKV ELYRIKFKES FAEMNRGSNE WKTVVGGAMF FIGFTALVIM WQKHYVYGPL PQSFDKEWVA KQTKRMLDMK VNPIQGLASK WDYEKNEWKK (1-169 aa encoded by BC021236)
靶标信息
Cytochrome c oxidase (COX) is the terminal enzyme of the mitochondrial respiratory chain. It is a multi-subunit enzyme complex that couples the transfer of electrons from cytochrome c to molecular oxygen and contributes to a proton electrochemical gradient across the inner mitochondrial membrane. The complex consists of 13 mitochondrial- and nuclear-encoded subunits. The functions of the nuclear-encoded subunits are unknown but they may play a role in the regulation and assembly of the complex. COX4 (COX4I1) is one of the nuclear-coded polypeptide chains of cytochrome c oxidase, the terminal oxidase in mitochondrial electron transport.
仅用于科研。不用于诊断过程。未经明确授权不得转售。
生物信息学
蛋白别名: cox iv; COX IV-1; Cytochrome c oxidase polypeptide IV; Cytochrome c oxidase subunit 4 isoform 1, mitochondrial; cytochrome c oxidase subunit IV; Cytochrome c oxidase subunit IV isoform 1; FLJ23483; MGC72016
基因别名: COX IV-1; COX4; COX4-1; COX4I1; COXIV; COXIV-1
UniProt ID: (Human) P13073
Entrez Gene ID: (Human) 1327



